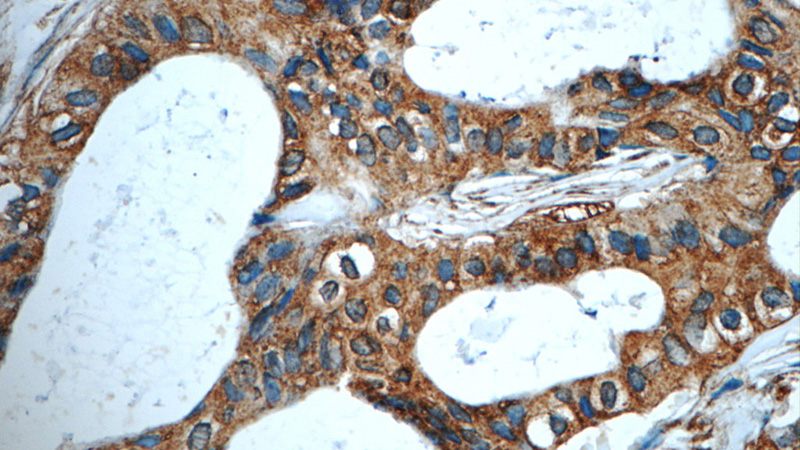
Immunohistochemistry of paraffin-embedded human breast cancer tissue slide using Catalog No:107376(LGALS3BP Antibody) at dilution of 1:50 (under 40x lens)

-
Product Name
LGALS3BP antibody
- Documents
-
Description
LGALS3BP Mouse Monoclonal antibody. Positive IHC detected in human breast cancer tissue, human skin cancer tissue. Positive WB detected in human blood tissue. Positive IP detected in human plasma tissue. Observed molecular weight by Western-blot: 90 kDa
-
Tested applications
ELISA, WB, IHC, IP
-
Species reactivity
Human; other species not tested.
-
Alternative names
90K antibody; BTBD17B antibody; Galectin 3 binding protein antibody; LGALS3BP antibody; M2BP antibody; Mac 2 binding protein antibody; MAC 2 BP antibody; MAC2BP antibody; Tumor assOCiated antigen 90K antibody
-
Isotype
Mouse IgG2b
-
Preparation
This antibody was obtained by immunization of LGALS3BP recombinant protein (Accession Number: NM_005567). Purification method: Caprylic acid/ammonium sulfate precipitation.
-
Clonality
Monoclonal
-
Formulation
PBS with 0.1% sodium azide and 50% glycerol pH 7.3.
-
Storage instructions
Store at -20℃. DO NOT ALIQUOT
-
Applications
Recommended Dilution:
WB: 1:1000-1:10000
IP: 1:500-1:5000
IHC: 1:20-1:200
-
Validations

human blood tissue were subjected to SDS PAGE followed by western blot with Catalog No:107376(LGALS3BP Antibody) at dilution of 1:2000
Immunohistochemistry of paraffin-embedded human breast cancer tissue slide using Catalog No:107376(LGALS3BP Antibody) at dilution of 1:50 (under 40x lens)

Immunohistochemistry of paraffin-embedded human breast cancer tissue slide using Catalog No:107376(LGALS3BP Antibody) at dilution of 1:50 (under 10x lens)

IP Result of anti-LGALS3BP (IP:Catalog No:107376, 5ug; Detection:Catalog No:107376 1:1000) with human plasma tissue lysate 4000ug.
-
Background
The galectins are a family of beta-galactoside-binding proteins implicated in modulating cell-cell and cell-matrix interactions. LGALS3BP is a widely expressed, secreted galectin. It has been found elevated in the serum of patients with various types of breast, lung, colorectal, ovary, and endometrial cancer, and in those infected by the human immunodeficiency virus (HIV). High expression levels of LGALS3BP are associated with a shorter survival, the occurrence of metastasis or a reduced response to chemotherapy. The native protein binds specifically to a human macrophage-associated lectin known as Mac-2 and also binds galectin 1. It appears to be implicated in immune response associated with natural killer (NK) and lymphokine-activated killer (LAK) cell cytotoxicity. Immunoblotting showed that LGALS3BP is likely contained in breast milk, serum, semen, saliva, urine, and tears.
Related Products / Services
Please note: All products are "FOR RESEARCH USE ONLY AND ARE NOT INTENDED FOR DIAGNOSTIC OR THERAPEUTIC USE"
